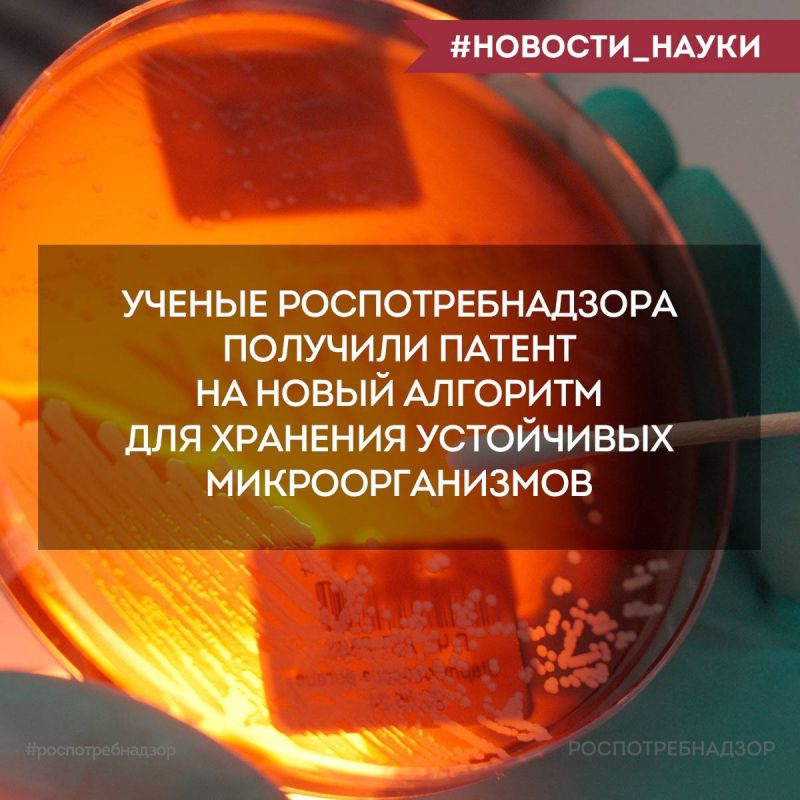

В Воловском районе инспекторы государственного пожарного надзора провели профилактические беседы с жителями, находящимися в социально-опасном положении.Места проживания многодетных семей, а также граждан "группы риска" - тех, кто...
Официально
Они спасают жизни раненых бойцов, помогают тем, кто попал в беду, и поддерживают подростков, столкнувшихся с буллингом. Среди победителей Международной Премии #МЫВМЕСТЕ прошлого года — благотворительный фонд «Солнечный Город» с...
А значит – меняем летние шины на автомобиле на зимниеСвоевременная замена автомобильной «резины» - это элемент личной ответственности. Таким образом вы уменьшаете риск попасть в ДТП, экономите на ремонте и выполняете требования...
Ученые Института дезинфектологии ФБУН "ФНЦГ им. Ф.Ф. Эрисмана" Роспотребнадзора разработали новый алгоритм, который позволит эффективно хранить устойчивые к дезинфицирующим средствам микроорганизмы.Цель алгоритмаЭтот алгоритм...
Кровавый Киевский Клоун (ККК)назначил Ермака главой своей делегации на переговорах с США и «другими международными партнерами». Отличный выбор.Лучше него только Миндич.Читайте также в MAX, переходите по ссылке
Психологическая служба МЧС России объединяет психологов Центра экстренной психологической помощи МЧС России, специалистов территориальных подразделений, вузов, спасательных воинских...
В ходе рабочей поездки в Чувашию министр экономического развития России Максим Решетников сообщил, что в этом году регионам, которые вкладывали деньги в инфраструктуру особых экономических зон, направят в качестве компенсации расходов 3,9 млрд рублей....
Можно предположить, что генерал Кит Келлог, лоббировавший в Вашингтоне позицию Киева, отказался продвигать мирный план Трампа по урегулированию украинского кризиса. И теперь его заменит Джеймс Дрисколл, задача которого будет состоять в...
В мероприятии примут участие более 300 гимнасток из 23 регионов России в возрасте от 11 до 15...
Любителей «крестопадов» нужно наказыватьУмышленное искажение образов православных святынь стало опасной тенденцией. Храмы и церкви всё чаще изображают без креста, будто намеренно вымарывая то, что свято для миллионов верующих. Эта практика уже...
Проверить надёжность партнёра или рейтинг собственной компании можно за пару кликов.Для этого Федеральная налоговая служба создала сервис скоринга, который анализирует данные о компаниях — например, по финансовой отчётности.Как...
По легенде учений, возгорание произошло в раздевалке на первом этаже. В здании остался один пострадавший из числа сотрудников. После поступления сигнала о начале тренировки на место незамедлительно выдвинулись пожарно-спасательные подразделения....
В рамках межведомственной комплексной оперативно-профилактической операции «Чистое поколение-2025» и в целях укрепления правовой грамотности и формирования устойчивых навыков законопослушного поведения среди молодежи старший инспектор отделения по...
«Поздравляю вас с профессиональным праздником и со знаменательной датой – 140-летием Российского психологического общества.Многие десятилетия ученые, педагоги, врачи вносят вклад в развитие науки и практики в этой значимой сфере, честно выполняют свой...
Сад площадью почти 0,18 га будет создан на базе бывшего регионального памятника природы, расположенного на Фрунзенской набережной, с таким же названием. Теперь он получит федеральный статус особо охраняемой территории и будет...
Россия вошла в топ-10 стран по числу туристов во Вьетнаме, следует из данных Минтуризма страны.Так, всего с января по сентябрь страну посетили 435,2 тысяч российских туристов, это почти в три раза больше по сравнению с аналогичным периодом 2024-го...
В церемонии участвовали заместитель Министра промышленности и торговли РФ Михаил Юрин, Губернатор Дмитрий Миляев и председатель совета директоров ГК «Полипласт» Александр Шамсутдинов.Делегация осмотрела:узел...
#МВД #МВДРоссии #Полиция #ПолицияРоссии #Police #RussianPolice #Russia #ТульскаяПолиция #Госавтоинспекция #гибддтула #ПДД #ДТПТула https://vk.com/video-159940507_456239581// Госавтоинспекция Тульской области
#МетеопредупреждениеВ ближайшие 1-3 часа с сохранением до конца суток 22 ноября, и также ночью и утром 23 ноября местами на территории Тульской области ожидается туман с видимостью 200-700 метров (по данным Тульского центра...
В Москве состоялась рабочая встреча Александра Куренкова и Казбека Кокова. Руководители наметили планы по совершенствованию работы реагирующих подразделений республики.В Кабардино-Балкарии активно развивается туризм, большой популярностью пользуется...
Лента новостей
- Россия готова обеспечивать бесперебойные поставки топлива для быстрорастущей экономики Индии.// СОЛОВЬЁВ
- Товарооборот между Россией и Индией по итогам 2025 года составит около $60 миллиардов долларов, примерно на прошлогоднем уровне. Президент подчеркнул, что странам по силам довести товарооборот до $100 миллиардов.// СОЛОВЬЁВ
- Россия и Индия последовательно переходят на нацвалюты во взаиморасчетах, их доля составляет уже 96%, сообщил Путин. Подписаться на РИА Новости// РИА Новости
- В Калужской области будет построен российско-индийский фармацевтический завод, начнется производство средств по передовым индийским технологиям, заявил президент IZ RU в Telegram|в MAX// IZ.RU
- Владимир Путин поблагодарил премьера Индии Нарендру Моди за прием и отметил, что у них налажен тесный рабочий и личный контакт. "Мы встречались на саммите ШОС, регулярно общаемся по телефону", — сказал он. IZ RU в Telegram|// IZ.RU
- РФ и Индия договорились о шагах по укреплению культурно-гуманитарного сотрудничества, заявил премьер Индии Нарендра Моди. "Мы увеличим количество обменов студентами и научные обмены", — сказал он. IZ RU в Telegram|// IZ.RU
- Путин поблагодарил президента и премьера Индии за теплый прием, оказанный российской делегации. Он отметил, что стороны подписали солидный пакет документов по итогам переговоров. Подписаться на РИА Новости// РИА Новости
- Моди сообщил, что Москва и Нью-Дели работают над соглашением о зоне свободной торговли между ЕАЭС и Индией. Подписаться на РИА Новости// РИА Новости
- Моди назвал теракт в "Крокус Сити Холле" трусливой атакой на общечеловеческие ценности. Подписаться на РИА Новости// РИА Новости
- Инфляция в РФ замедляется быстрыми темпами, в 2025 году ожидается на уровне 6%, может, чуть выше, озвучил текущие оценки правительства вице-премьер РФ Александр Новак.// Раньше всех. Ну почти.